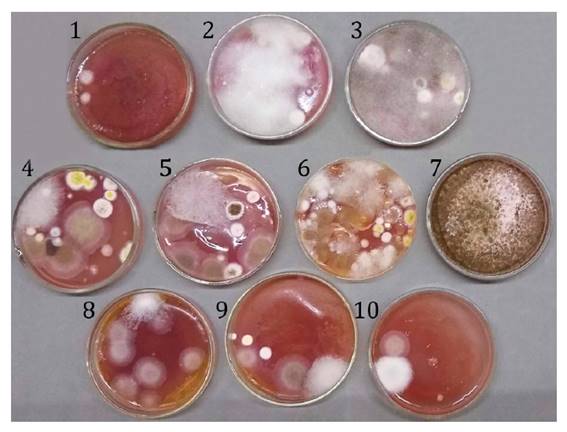

Revista de la Facultad de Ciencias
Agrarias. Universidad Nacional de Cuyo. Tomo 55(2). ISSN (en línea) 1853-8665.
Año 2023.
Original article
Characterization
of Argentine commercial bee pollen intended for human consumption
Caracterización
de polen apícola comercial de Argentina destinado a consumo humano
Victoria
Fernández Etchegaray1,
Gisela
Grandinetti1,
Matías Francisco
Ledesma González1,
Sandra Karina
Medici2,
1Universidad
Nacional del Sur (UNS). Departamento de Agronomía. Laboratorio de Estudios
Apícolas (LabEA-CIC). San Andrés 800. Bahía Blanca. Buenos Aires. Argentina.
2Universidad
Nacional de Mar del Plata (UNMDP). Facultad de Ciencias Exactas y Naturales
(FCEyN). Centro de Investigación en Abejas Sociales (CIAS). Funes 3350. 7600.
Mar del Plata. Argentina.
3Universidad
Nacional de La Plata. Facultad de Ciencias Agrarias y Forestales. CIDEFI.
Calles 60 y 119 S/N. 1900. La Plata. Argentina.
4Comisión
de Investigaciones Científicas de la Provincia de Buenos Aires (CIC). Calle 526
entre 10 y 11 -1900 La Plata. Buenos Aires. Argentina.
*lafernan@uns.edu.ar
Abstract
Bee pollen is
consumed as a dietary supplement. Its quality parameters are regulated by the
Argentine Food Code (AFCode). The present study characterized 10 commercial
dehydrated samples from five Argentine provinces to provide information on
hygienic quality and health safety. We assessed their microbiological quality,
including potential mycotoxins. We also determined their botanical origin and
moisture. Results showed that seven out of ten samples presented lower counts
of culturable heterotrophic mesophilic bacteria tan those allowed by the
AFCode. In contrast, all samples showed higher filamentous fungi and yeast
counts than the level approved by the AFCode. No fumonisin or deoxynivalenol
was detected; we observed only aflatoxin B2 in one sample and ochratoxin A in
two. The results of the botanical origin of samples showed that all samples had
a predominant pollen type, except one. The microbiological quality of all
samples agreed with that required by the AFCode, except filamentous fungi and
yeasts. In addition, we found variations among samples from the same province.
Therefore, if pollen is intended for human consumption, appropriate hygiene
standards must be applied to all bee pollen production operations.
Keywords: Apis mellifera, Argentina, bee
pollen, microbiological quality, botanical origin
Resumen
El polen apícola
se consume como suplemento dietético y su calidad está regulada por el Código
Alimentario Argentino (CAA). Este estudio caracterizó 10 muestras deshidratadas
comerciales de cinco provincias argentinas, para brindar información sobre
calidad higiénica y seguridad sanitaria. Evaluamos la calidad microbiológica y
la presencia de micotoxinas. Determinamos el origen botánico y la humedad. Los
resultados demostraron que siete de 10 muestras presentaron recuentos de
bacterias aerobias mesófilas y estos fueron menores que el nivel permitido por
el CAA. Por el contrario, todas las muestras presentaron recuentos de hongos
filamentosos y levaduras superiores al nivel permitido en el CAA. No se
detectaron fumonisinas ni deoxinivalenol, solo aflatoxina B2 en una muestra y
ocratoxina A en dos muestras. Los resultados del origen botánico mostraron que,
a excepción de una, todas las muestras presentaron un tipo polínico
predominante: en Buenos Aires fue Brassicaceae y en Chubut fueron Cytisus
scoparius y Cichorieae. La calidad microbiológica estuvo de acuerdo
con el CAA, a excepción de hongos y levaduras y se observaron variaciones entre
muestras de la misma provincia. Se concluye que, si el polen apícola se destina
al consumo humano, se deben aplicar normas de higiene adecuadas en todas las
operaciones de producción.
Palabras clave: Apis mellifera, Argentina,
polen apícola, calidad microbiológica, origen botánico
Originales: Recepción: 23/06/2023- Aceptación: 26/09/2023
Introduction
Apis
mellifera L. collects pollen from different flowers for brood rearing.
During collecting trips, they pack floral pollen grains into pollen pellets
(pollen loads), mixing them with nectar and saliva. These pollen loads are
called bee pollen (BP) (48). Its
composition strongly depends on plant species, geographic origin, and factors
such as climatic conditions, soil type, and beekeeping activities (16). Crane (1990)
states that BP production is the second most important bee product. Nowadays,
tons of pollen, either processed or unprocessed, are sold for human and animal
consumption (11).
Beekeepers
collect BP from hives using special pollen traps and transport it to the
processing unit (41). Generally,
processing involves cleaning, freezing, thawing, dehydration, packaging,
transportation, and marketing. The dehydration process aims to increase
product’s shelf life. In nature, BP contains 20-30 g x 100 g-1 of water
(moisture) and has a water activity ranging from 0.66 to 0.82, providing a
favorable matrix for the proliferation of microorganisms and possible chemical
and enzymatic reactions (40). In
addition, if a long period elapses between pollen collection and consumption as
a food supplement, mycotoxins produced by toxicogenic fungi could be produced (33). Consequently, microbiological contamination
is one of the most important criteria to determine BP quality intended for
human consumption.
BP
is consumed as a dietary supplement, and its quality parameters are regulated
by the Argentine Food Code (AFCode) under article 785. According to this code,
the máximum molds and yeasts level allowed for trading purposes is 100 colony-forming
units (CFU) g-1 of BP and 150 x 103 CFU g-1 for non-pathogenic aerobic
microorganisms. Nevertheless, the legislation does not allow the presence of
aerobic pathogenic microorganisms without specification of genera or species.
Legislated quality standards and limits for BP do not exist in the European
Union or internationally. For example, the United States Food and Drug
Administration (FDA) does not consider BP an additive. As previously mentioned,
only a few countries, such as Brazil, Poland, Switzerland, Bulgaria, China, and
Argentina, have established criteria for BP for human consumption (35). To our knowledge, there are few publications
on the microbiological characteristics of BP ready to be sold in the retail market
(5, 12, 14, 40, 48), and only two studies
are from Argentina (9, 34).
Accordingly,
we previously investigated the microbiological and chemical characterization of
36 BP samples of beekeepers from the Southwest of Buenos Aires Province,
Argentina, at four sampling stage points of the production process (27). We also studied the traceability of
potential enterotoxic Bacillus cereus strains, showing that BP could be
contaminated at any point, emphasizing the importance of hygienic processing to
avoid
spore contamination (37). Moreover, we
identified the aerobic spore-forming species in the microbiota of fresh BP
samples intended for human consumption obtained in the main producing areas of
Argentina (4). On the other hand, we
evaluated whether properly processed BP could be conserved for more than 12
months without showing alterations in its microbiological and chemical
qualities (26). Hence, the present
investigation aims to characterize 10 commercial dehydrated BP samples from
five different Argentine provinces, providing information on hygienic quality
and health safety of what we consume. Therefore, we assessed microbiological
quality, including potential mycotoxins while determining sample botanical
origin and moisture.
Materials
and methods
Bee
pollen samples
Ten BP samples
from five different provinces of Argentina were included in this study. All samples
were purchased directly from supermarkets between April and May 2022 and were identified
by progressive numbers from 1 to 10. All were sold as dried bulk products and stored
at 4°C until testing. The gravimetric method was used for moisture determination
(23). Briefly, two grams of each BP
sample were dried in an oven at 60 ± 2°C, up to constant weight. Results were
expressed in g %.
Microbiological
characterization
Counts of
filamentous fungi (FF), yeasts (Y), and culturable heterotrophic mesophilic bacteria
(CHMB) were evaluated as previously described (25).
Ten grams of each BP simple were homogenized into 90 ml of peptone water
(Britania®, Argentina) (initial suspension). Decimal serial dilutions were
performed using sterile distilled water. After incubation, the number of FF and
Y was determined by counting in a range of 10 to 100 and 15 to 300 for CHMB.
Enterobacteriaceae (ENT) were counted on Violet Red Bile Glucose Agar (VRBGA, Britania®)
at 32°C for 24-48 h. Microbial counts were carried out in triplicate, and
results were expressed as log10 colony-forming units g-1 (log10 CFU g-1).
Complementary
microbiological determination
Aerobic
spore-forming bacteria belonging to the Bacillus cereus sensu lato group
were assessed as described by Alippi et al. (2022).
The number of colonies was averaged, and the total colony-forming units (CFUs)
were calculated per g of BP (CFU g-1).
Isolation and identification
of Bacillus species within the Cereus clade (30)
were made according to previously published methods (36,
37). After the heat-treatment step, 100 μl of the sediment-fluid
mixture was poured in triplicate over the surface of polymyxin-pyruvate-egg-yolk-mannitol-agar
(PEMBA) plates (Britania®, Argentina). Plates were incubated at 37°C and
examined for bacterial growth daily and for up to 5 days (37). Presumptive colonies of B. cereus, i.e.,
turquoise blue crenated colonies (mannitol negative) surrounded by opaque zones
of egg-yolk precipitation (lecithinase positive), were counted and re-streaked
in Bacillus Chromoselect agar (Sigma-Aldrich®). Typical colonies were selected,
i.e., blue with dark blue centers, showing a pinkish-beige pigmentation
of the medium (3); colors of colonies and
substrate were compared with a Pantone international chart and identified with
a PMS number (http://www.cal-print.com/InkColorChart.htm) (2). Presumptive B. cereus isolates were
tested as described by López & Alippi (2007).
Mycotoxin
analysis
Aflatoxins B1,
B2, G1, G2, fumonisins B1 and B2, ochratoxin A, and deoxynivalenol (DON) content
of BP were analyzed using UHPLC-MSMS (8).
One gram of each sample was weighed into a 15 ml plastic tube, and 2 ml of
methanol was added. The mixture was shaken for 2 min and then centrifuged at
3500 rpm for 5 min. The supernatant was filtered into a vial through a 0.45 μm
syringe filter and run with LC-MS/MS. The chromatographic conditions were the
following: run time, 10 min; injection volume, 50 μL, column ACQUITY UPLCr BEH C18
1.7 μm, flow: 0.300ml/min and the mobile phase C: 500 grams of water, 20.8
grams of methanol (UPLC), 400 μL of formic acid and 335 μL of ammonia (30%).
Detection limits (LD) obtained with this technique were: aflatoxins B1, B2, G1,
G2 0.1 μg.kg-1; ochratoxin A 0.1 μg.kg-1; fumonisins B1, B2 0.1 μg.kg-1, and
DON 0.1 μg.kg-1.
Botanical
origin
The
palynological identification of BP was performed with the method described by Armaza (2013) in samples from the provinces of Buenos
Aires and Chubut. Briefly, a simple of 4 g, corresponding to approximately 300
pollen pellets, was considered representative of botanical origin. Pollen loads
were analyzed under a stereoscopic microscope and sorted by color, shape, and
texture, assuming each pellet was a homogeneous mass of pollen from a single
plant (45). To perform the microscopic
observations, pollen grains from pellets were mounted on slides using the
technique proposed by Wodehouse (1935). When this technique
was not adequate to determine pollen grain structure, the microacetolysis method
(46) was used. Thus, the botanical origin
of some samples was described onlywith the Wodehouse technique, and other
samples required both. The pollen grains were identified by comparison with the
existing pollen collection at the Departamento de Agronomía (Universidad
Nacional del Sur, Buenos Aires, Argentina). Therefore, only six out of ten
samples were analyzed. Those samples corresponding to its area of influence
(from Buenos Aires to the south of the country) were analyzed. Pollen types
were identified up to a species level or genus and up to tribe or family level
when the morphology of pollen grains allowed no distinction. Each identified
pollen load was weighed, and results were expressed as a percentage of total
weight (43). The percentages assigned to
each pollen type were expressed as predominant pollen (>45%), secondary
pollen (45-16%), minor pollen (15-3%), and traces of minor pollen (<3%)
using pollen frequency classes by Louveaux
(1978).
Statistical
analysis
Data from FF, Y,
and CHMB counts in the 10 BP samples were analyzed by one-way analysis of
variance using InfoStat software (21).
When a significant F-value was detected, means were compared with the LSD test
(p<0.05).
Results
and discussion
Microbial
enumeration of FF, Y, CHMB, ENT, and moisture were performed to ensure that all
samples collected were hygienically processed and conformed to the current
microbial criteria set in the AFCode (table 1). Moisture is
among the most relevant factors affecting BP microbiological quality and
conservation (6).
Table
1. Microbiological determination in 10 bee
pollen samples obtained directly from supermarkets in five different Argentine
provinces.
Tabla 1. Determinaciones
microbiológicas en 10 muestras de polen apícola obtenidas de supermercados de
cinco provincias de Argentina.

FF and Y: filamentous fungi (FF) and yeast (Y);
CHMB: culturable heterotrophic mesophilic bacteria; ND: undetected, 0 colonies.
*Results are the mean of three replicates and ± its standard deviation. Letters
in bold represent that bee pollen samples were different by LSD test with a
significance of p = 0.05.
FF-Y: hongos filamentosos y levaduras; CHMB:
recuento de bacterias aerobias mesófilas; ND: no detectable, sin colonias. *Los
resultados se expresan como la media de tres réplicas y ± su desviación
estándar. En negrita, las letras representan que las muestras fueron diferentes
con el test de LSD, con un nivel de significancia de p = 0,05.
The safe
humidity level was lower than 8% (AFCode), while the moisture of the studied
dried BP samples varied between 4 and 9.4%. Only two samples had more humidity
than allowed and showed higher FF and Y. Concerning CHMB populations, seven out
of ten samples revealed microorganisms counts ranging from 3.23 log CFU g-1
(1.725 CFU g-1 BP) to 3.97 log CFU g-1 (18.750 CFU g-1 BP). There were no
statistical differences between them, all showing lower CHMB than that allowed
by the AFCode (150 x 103 CFU or 5.17 log g-1 of BP for non-pathogenic aerobic microorganisms).
In contrast, all samples showed FF and Y counts higher than those approved by
the AFCode (100 CFU or 2 log g-1 of BP). Counts for FF and Y ranged from 2.85
log CFU g-1 (725 CFU g-1 BP) to 4.93 log CFU g-1 (85.750 CFU g-1 BP). Several
studies on BP from different regions of the world exceeded? the limit of FF and
Y established in the AFCode (11, 12, 24, 32, 40, 47, 51). In this sense, our
group in 2020 suggested the AFCode to modify this number to 5 x104 CFU per g of
BP, as proposed by Campos et al. (2008). This
modification is being treated (19). Enterobacteriaceae
colonies were not detected in any of the BP samples studied. However, some
fungal species developed after incubation at 37°C for 24 h on Petri dishes
containing VRBGA. As shown in figure 1, these fungi grew in
the plates with the selective medium used to search for enterobacteria in all
samples. Fernández et al. (2020, 2021) also observed
the growth of fungi in those media when studying BP samples from Argentina.
Figure 1. Filamentous
fungi observed in the selective culture medium Violet Red Bile Glucose Agar
when looking for enterobacteria at 37°C after one day of incubation.
Figura 1. Hongos
filamentosos observados en medio selectivo Agar Violeta Rojo Bilis Glucosa para
conteo de enterobacterias a 37°C luego de un día de incubación.
These
observations may be explained by the fact that some filamentous fungi can
biodegrade different dyes, such as those in VRBGA medium, i.e., neutral
red and crystal violet (1, 15, 31).
Species belonging to the Cereus clade were detected in seven out of ten
samples, ranging between 100 CFU g-1 and 1.650 CFU g-1 of BP (table
1). These values complied with the food safety criteria for B. cereus (<105
CFU g-1) (22). Colony counts revealed no
statistically significant differences among the means of the samples.
We identified 13
isolates of presumptive B. cereus according to colony morphology in
selective and differential media. All isolates were Gram-positive and
catalase-positive. Stained microscopic preparations showed ellipsoidal spores
in a central position, not distending the sporangia, and the cytoplasm was
filled with unstained globules (figure 2).
Figure 2. Gram-stained
microscopic preparation of B. cereus isolate (7.2) from simple number 7
of Buenos Aires province, showing ellipsoidal spores in a central position, not
distending the sporangia, and cytoplasm filled with unstained globules.
Figura 2. Tinción
de Gram de un aislamiento de B. cereus de una muestra de la provincia de
Buenos Aires, donde se observan esporas elipsoidales en posición central, sin
distensión de esporangios y citoplasma con glóbulos sin teñir.
Similarly, 12
isolates exhibited hemolytic activity of β hemolysis, and one (isolate 7.2)
showed a discontinuous hemolytic pattern in sheep blood agar plates (10), probably due to the production of hemolysin
BL. In PEMBA plates, isolates produced crenated colonies retaining the
turquoise blue of the pH indicator because of their inability to ferment
mannitol, acidifying the medium and generating an egg-yolk precipitation halo
as a result of lecithinase activity. Moreover, when growing on Bacillus Chromoselect
agar, 12 isolates showed large blue colonies [PMS 2746] with dark blue centers
and pinkish beige color [PMS 152] of the medium, and only isolate 8.4 exhibited
green colonies [PMS 361] with yellow color [PMS 114] of the basal medium.
The presence of B.
cereus in Argentine pollen samples has been previously reported (4, 27, 37). Results obtained here were similar to
those regarding spore counting that complied with the food safety criteria for B.
cereus (< 105 CFU g-1) (22, 39).
Concerning mycotoxins, none of the fumonisins nor DON was detected in the BP
samples analyzed. Only aflatoxin B2 was detected in one sample, number 10, out
of 10 (10%) in a concentration of 0.2 μg.kg-1 and ochratoxin A in two samples,
2 and 7, both in a concentration of 0.3 μg.kg-1. Aflatoxin B1 is among the
hazardous toxic substances produced by Aspergillus (2017). Nevertheless,
these mycotoxin levels were far from the limits allowed in humans (10 μg.kg-1)
by regulations for other foods. Research on the presence of mycotoxins in BP,
in general, is particularly scarce. Medina et al. (2004)
stated that BP could constitute a significant risk factor in the diet of
consumers by the presence of ochratoxin Shepard et
al. (2013) described zearalenone as the main mycotoxin in BP. Cirigliano et al. (2014) studied in vitro mycotoxins
produced by two species of fungi isolated from BP. None of the previous works
analyzed the presence of mycotoxins in BP samples for human consumption. García Villanova et al. (2004) examined 20
commercial BP samples from Spain for aflatoxins B1, B2, G1, G2, and ochratoxin
A. None showed quantifiable values of the aforementioned mycotoxins. Carrera et al. (2023) studied five mycotoxins
(aflatoxin B1, ochratoxin A, zearalenone, deoxynivalenol, and toxin T2) in 80
BP samples from diverse climatic areas, organic and conventional beekeeping,
with different floral composition and commercial format (fresh, dry, or bee
bread). According to these studies, the most widespread mycotoxins in BP were
aflatoxin B1, DON, ZEN, OTA, and T-2. In 28 % of the cases analyzed,
deoxynivalenol exceeded safe limits, while aflatoxin B1, due to its generally
high concentration, caused major public health concern in 84 % of the cases. It
is important to note that legislation of the European Union establishes
regulations on mycotoxins for a variety of foods, but almost no regulation has
been issued on these metabolites in BP.
Variation in
microbiological quality was found among samples from the same province (table 1; table 2). All samples from Chubut
province exhibited higher counts of FF and Y than the rest of the samples
studied (table 2).
Table
2. Counting the range of microorganisms in
dehydrated bee pollen samples according to each Argentine province.
Tabla 2. Conteo
de microorganismos en muestras de polen apícola deshidratado según cada
provincia.

Mean value ± standard deviation; b Minimum - maximum
value ± standard deviation.
a
Media ± desviación estándar; b Valores mínimos - máximos ± desviación estándar.
Regarding CHMB,
all BP samples showed similar counts, independently of their geographical
origin. It is known that each piary has different collection and processing
practices. Thus, the variation in the counts of microorganisms observed, even
between samples from the same province, is aceptable considering apiary
manipulation. On the other hand, the microbiological quality of all samples
complied with article 785 from the AFCode, except for FF and Y. Therefore, if
pollen is intended for human consumption, appropriate hygiene standards must be
applied in all BP production operations. Proper BP handling and sanitation
practices would improve microbiological quality (27,
49).
Regarding
botanical origin, all BP samples analyzed were pollen mixtures, verified by
identifying numerous botanical species (table 3).
Table
3. Botanical composition of bee pollen
samples from Buenos Aires and Chubut provinces.
Tabla 3. Composición
botánica de las muestras de polen apícola de Buenos Aires y Chubut.

P= predominant pollen (> 45%); S= secondary
pollen (16-45 %); IM= minor pollen (3-15 %); t= traces or minor pollen (<
3%).
P= polen dominante (> 45%); S= polen secundario
(16-45 %); IM= menor importancia (3-15 %); t= trazas (< 3%).
However,
according to Louveaux’s classification (38),
most samples were monofloral. Only the Trevelín sample from Chubut province was
multifloral. The determination of monoflorality is significant since it could
increase the economic value of the product, and it seems to be correlated to
the abundance of bioactive compounds, such as polyphenols and flavonoids (44). Nevertheless, unlike honey, no regulation in
our AFCode specifies the botanical origin of BP.
The Brassicaceae
type (figure 3) was dominant in BP samples from Buenos Aires
province (table 3), with Diplotaxis tenuifolia (“flor
amarilla”) showing a strong presence.
Figure 3. Brassicaceae
type which was dominant in bee pollen samples from Buenos Aires province.
Figura 3. Tipo
Brassicaceae fue dominante en las muestras de polen apícola de la provincia de
Buenos Aires.
This species,
which belongs to a stenopalynous family, is of central importance in the
contribution of nectar and pollen to the semiarid region of this province (52). On the other hand, BP samples from Chubut
province showed the greatest floral diversity. El Hoyo (sample 9) showed the
predominant Cichorieae type (figure 4), whereas Lago Puelo
displayed Cytisus scoparius (figure 5).
Figure 4. Cichorieae
type which was dominant in bee pollen samples from El Hoyo, simple 9 from
Chubut province.
Figura 4. Tipo
Cichorieae fue dominante en la muestra 9 de El Hoyo perteneciente a la
provincia de Chubut.
Figure 5. Cytisus
scoparius, dominant in bee
pollen samples from El Hoyo, sample 9 from Chubut province.
Figura 5. Cytisus
scoparius fue dominante en
la muestra 9 de El Hoyo perteneciente a la provincia de Chubut.
All samples from
Chubut province presented species of typical trees and shrubs of southern
Argentina, which are geographical markers of pollen from that region (28), such as Maytenus boaria (“maitén”), Nothofagus
sp. (“lenga”), and Azorella prolifera (“neneo”).
Conclusions
All the samples
studied in this work, no matter the province nor the botanical origin, complied
with the AFCode, except FF and Y. These results gave us more scientific support
to make changes in our legislation, as we are doing, and to underline the
importance of hygienic processing of BP to avoid microbial contamination.
Further research should focus on two aspects not regulated in our AFCode nor in
the legislation of the European Union: the presence/absence and quantity of
mycotoxins and the importance of evaluating botanical origin. Both subjects
will broaden our knowledge and legislation in terms of BP to know what we are
consuming.
Acknowledgements
This study was
financed by “Desafíos de la apicultura en el sur bonaerense”, PGI 24/A248 - UNS.
We would like to thank Cooperativa de Trabajo Apícola Pampero, Diego Iaconis,
Coop Sol (René Sayago), Catalina Isgró, Magalí Marco, and José Mozzi for
providing all bee pollen samples. We would also like to thank Josefina Cabrera
Durango for her critical reading of the manuscript and Laura Chantal Milan for
her help with botanical origins.
1. Ali, H.;
Khan, M.; Idrees, M.; Ahmad Jan, S. 2012-2013. Biological decolorization of
crystal violet by Alternaria solani. International Journal of Green and
Herbal Chemistry. 2(1): 31-38.
2. Alippi, A. M.
2019a. Data associated with the characterization and presumptive identification
of Bacillus and related species isolated from honey samples by using
HiCrome Bacillus agar. Data in Brief. 25: 104206. DOI:
https://doi.org/10.1016/j.dib.2019.104206
3. Alippi, A.
M.; Abrahamovich, E. 2019b. HiCrome Bacillus agar for presumptive
identification of Bacillus and related species isolated from honey
samples. International Journal of Food Microbiology. 305: 108245. DOI: https://doi.org/10.1016/j.ijfoodmicro.2019.108245
4. Alippi, A.
M.; Fernández, L. A.; López, A. C. 2022. Diversity of aerobic spore-forming
bacteria isolated from fresh bee pollen intended for human consumption in
Argentina. Journal of Apiculture Research. 61(3): 392-399. DOI:
https://doi.org/10.1080/00218839.2021.1960747
5. Altintas, L.;
Sevin, S.; Kahraman, H. A.; Tutun, H.; Sababoglu, E.; Keyvan, E. 2022.
Microbiological characterization of fresh bee pollens from the Aegean region of
Turkey. Journal of the Hellenic Veterinary Medical Society. 73(1): 3845-3852.
DOI: https://doi.org/10.12681/jhvms.26020
6. Anjos, O.;
Paula, V.; Delgado, T.; Estevinho, L. M. 2019. Influence of the storage
conditions on the quality of bee pollen. Zemdirbyste-Agriculture. 106(1):
87-94. DOI: https://doi.org/10.13080/z-a.2019.106.012
7. Armaza, A. C.
2013. Polen corbicular colectado por Apis mellifera L.: importancia del
tamaño de muestra. Trabajo Final. Tecnicatura Universitaria Apícola.
Universidad Nacional del Sur. Bahía Blanca.
8. Azaiez, I.;
Giusti, F.; Sagratini, G.; Mañes, J.; Fernández-Franzón, M. 2014.
Multi-mycotoxins Analysis in Dried Fruit by LC/MS/MS and a Modified QuEChERS
Procedure. Food Analytical Methods. 7: 935-945. DOI:
https://doi.org/10.1007/s12161-013-9785-3.
9. Baldi, B.;
Grasso, D.; Chaves Pereira, S.; Fernández, G. 2004. Caracterización
bromatológica del polen apícola argentino. Ciencia Docencia Tecnología. 29:
145-181.
10. Beecher, D.
J.; Wong, A. C. 1994. Identification of hemolysin BL-producing Bacillus
cereus isolates by a discontinuous hemolytic pattern in blood agar. Applied
and Environmental Microbiology. 60(5): 1646-1651. DOI:
https://doi.org/10.1128/aem.60.5.1646-1651.1994
11. Belhadj, H.;
Bouamra, D.; Dahamna, S.; Harzallah, D.; Ghadbane, M.; Khennouf, S. 2012.
Microbiological sanitary aspects of pollen. Advances in Environmental Biology.
6(4): 1415-1420.
12. Belhadj, H.;
Harzallah, D.; Dahamna, S.; Khennouf, S. 2014. Microbiological quality control
of marketed pollen. Scholar Research Library. 6(2): 37-42.
13. Bogdanov, S.
2017. Pollen: Production, Nutrition and Health: A Review. Bee Product Science. https://www.bee-hexagon.net/english/health/pollenbook2review
(Date of consultation: 05/06/2023).
14. Bonheví, J.;
Jorda, R. E. 1997. Nutrient composition and microbiological quality of honey
bee-collected pollen in Spain. Journal of Agricultural and Food Chemistry.
45(3): 725-732.
15. Bumpus, J.
A.; Brock, B. J. 1988. Biodegradation of crystal violet by the white rot fungus
Phanerochaete chrysosporium. Applied and Environmental Microbiology.
54(5): 1143-1150. DOI: https://doi.org/10.1128/aem.54.5.1143-1150.1988
16. Campos, M.
G. R.; Bogdanov, S.; Bicudo de Almeida-Muradian, L.; Szczesna, T.; Mancebo, Y.;
Frigerio, C.; Ferreira, F. 2008. Pollen composition and standardisation of
analytical methods. Journal of Apicultural Research. 47(2): 154-163. DOI:
https://doi.org/10.1080/00218839.2008.11101443
17. Carrera, M.
A.; Miguel, E.; Fernández-Alba, A. R.; Hernando, M. D. 2023. First survey on
the presence of mycotoxins in commercial bee pollen sourced from 28 countries.
Food Control. 152 (2023). DOI: https://doi.org/10.1016/j.foodcont.2023.109816
18. Cirigliano,
A. M.; Rodríguez, M. A.; Godeas, A. M.; Cabrera, G. M. 2014. Mycotoxins from
beehive pollen mycoflora. Journal of Scientific Research and Reports. 3(7):
966-972.
19. CONAL,
Comisión Nacional de Alimentos. 2020. Acta 135.
http://www.conal.gob.ar/sitio/_pdf/20200612111400.pdf. (Date of consultation:
09/06/2023).
20. Crane, E.
1990. Beekeeping: Science, Practice and World Recourses. Heinemann, London.
21. Di Rienzo,
J. A.; Casanoves, F.; Balzarini, M.; González, L.; Tablada, M.; Robledo, C. W.
2013. InfoStat Version, 2013. Argentina: Universidad Nacional de Córdoba.
22. EFSA BIOHAZ
Panel (EFSA Panel on Biological Hazards). 2016. Scientific opinion on the risks
for public health related to the presence of Bacillus cereus and other Bacillus
spp. Including Bacillus thuringiensis in foodstuffs. EFSA Journal.
14(7): 4524-93p.
23. Erdey, L.;
Pólos, L.; Chalmers, R. A. 1970. Development and publication of new gravimetric
methods of analysis. Talanta. 17(12): 1143-1155.
24. Estevinho,
L. M.; Rodrigues, S.; Pereira, A. P.; Feas, X. 2012. Portuguese bee pollen:
Palynological study, nutritional and microbiological evaluation. International
Journal of Food Science and Technology. 47(2): 429- 435. DOI:
https://doi.org/10.1111/j.1365-2621.2011.02859.x
25. Fernández,
L. A.; Ghilardi, C.; Hoffman, B.; Busso, C. A.; Gallez, L. M. 2017.
Microbiological quality of honey from the Pampas Region (Argentina) throughout
the extraction process. Revista Argentina de Microbiología. 49(1): 55-61.
26. Fernández,
L. A.; Rodríguez, M. A.; Sánchez, R.; Pérez, M.; Gallez, L. M. 2021. Long-term microbiological
and chemical changes in Argentinean bee pollen for human consumption: influence
of time and storage conditions. Journal
of Apicultural Research . 60(2): 319-325. DOI:
https://doi.org/10.1080/00218839.2020.1728867
27. Fernández,
L. A.; Susca Tromba, J.; Alippi, A. M.; López, F. M.; Pérez, M.; Gallez, L. M.
2020. Microbiological and chemical characterization of bee pollen throughout
the production process in the Southwest of Buenos Aires Province (Argentina). Journal of
Apicultural Research . 59(2): 156-159. DOI: https://doi.org/10.1080/00218839.2019.1702327
28. Forcone, A.;
García, J.; Ayestarán, G. 2006. Polen de las mieles de la Patagonia Andina (Chubut-Argentina).
Boletín de la Sociedad Argentina de Botánica. 41(1-2): 25-39.
29.
García-Villanova, R. J.; Cordón, C.; González Paramás, A. M.; García Rosales,
M. E. 2004. Simultaneous Immuno Affinity Column Cleanup and HPLC Analysis of
Aflatoxins and Ochratoxin A in Spanish Bee Pollen. Journal of Agricultural and
Food Chemistry. 52: 7235-7239.
30. Gupta, R.
S.; Patel, S.; Saini. N.; Chen, S. 2020. Robust demarcation of 17 distinct Bacillus
species clades, proposed as novel Bacillaceae genera, by
phylogenomics and comparative genomic analyses: description of Robertmurraya
kyonggiensis sp. nov. and proposal for an emended genus
Bacillus limiting it only to the members of the Subtilis and Cereus
clades of species. International Journal of Systematic and Evolutionary
Microbiology. 70(11): 5753-5798. DOI: https://doi.org/10.1099/ijsem.0.004475
31. Hasan
AI-Jawhari, I. F. 2015. Decolorization of methylene blue and crystal violet by
some filamentous fungi. International Journal of Environmental Bioremediation
and Biodegradation. 3(2): 62-65. DOI: https://doi.org/10.12691/ijebb-3-2-4
32. Kostic, A.
Z.; Petrovic, T. S.; Krnjaja, V. S.; Nedic, N. M.; Tešic, Ž. L.;
Milojkovic-Opsenica, D. M.; Barac, M. B.; Stanojevic, S. P.; Pešic, M. B. 2017.
Mold/aflatoxin contamination of honey bee collected pollen from different
Serbian regions. Journal
of Apicultural Research . 56(1): 13-20.
33. Kostic, A.
Z.; Milincic, D. D.; Petrovic, T. S.; Krnjaja, V. S.; Stanojevic, S. P.; Barac,
M. B.; Tešic, Ž. L.; Pešic, M. B. 2019. Mycotoxins and mycotoxin producing
fungi in pollen: review. Toxins (Basel). 11(2): 64. DOI:
https://doi.org/10.3390/toxins11020064
34. Libonatti,
C.; Andersen-Puchuri, L.; Tabera, A.; Varela, S.; Passucci, J.; Basualdo, M.
2017. Caracterización microbiológica de polen comercial. Reporte Preliminar.
Revista Electrónica de Veterinaria: 18(9): 10-15.
http://www.veterinaria.org/revistas/redvet/n090917/091775.pdf
35. Liolios, V.;
Tananaki, C.; Kanelis, D.; Rodopoulou, M. A. 2022. The microbiological quality
of fresh bee pollen during the harvesting process. Journal of
Apicultural Research . 1-11. DOI:
https://doi.org/10.1080/00218839.2022.2140924
36. López, A.
C.; Alippi, A. M. 2007. Phenotypic and genotypic diversity of Bacillus
cereus isolates recovered from honey. International
Journal of Food Microbiology . 117(2): 175-184. DOI:
https://doi.org/10.1016/j.ijfoodmicro.2007.03.007
37. López, A.
C.; Fernández, L. A.; Alippi, A. M. 2020. Traceability of potential
enterotoxigenic Bacillus cereus in bee-pollen samples from Argentina
throughout the production process. International
Journal of Food Microbiology . 334- 108816. DOI: https://doi.org/10.1016/j. ijfoodmicro.2020.108816
38. Louveaux,
J.; Maurizio, A.; Vorwohl, G. 1978. Methods of Melissopalynology. Bee World.
59(4): 139-157. DOI: https://doi.org/10.1080/0005772X.1978.11097714
39. Lucking, G.;
Stoeckel, M.; Atamer, Z.; Hinrichs, J.; Ehling-Schulz, M. 2013.
Characterization of aerobic spore-forming bacteria associated with industrial
dairy processing environments and product spoilage. International Journal of Food
Microbiology . 166(2): 270-279. DOI: https://doi.org/10.1016/j.ijfoodmicro.2013.07.004
40. Machado De
Melo, A. A.; Estevinho, M. L.; Bicudo de Almeida-Muradian, L. 2015. A diagnosis
of the microbiological quality of dehydrated bee-pollen produced in Brazil.
Letters in Applied Microbiology. 61: 477-483. DOI:
https://doi.org/10.1111/lam.12480
41. Margăoăn,
R.; Marghitas, L. A.; Dezmirean, D.; Mihal, C. M.; Bobis, O. 2010. Bee
collected pollen. General aspects and chemical composition. Bulletin of
University of Agricultural Sciences and Veterinary Medicine Cluj-Napoca. Animal
Science and Biotechnologies. 67: 1-2.
42. Medina, A.;
González, G.; Sáez, J. M.; Rufino, M.; Jiménez, M. 2004. Bee Pollen, a
Substrate that Stimulates Ochratoxin A Production by Aspergillus ochraceus. Systematic
and Applied Microbiology. 27: 261-267. DOI: https://doi.org/10.1078/072320204322881880
43. Montenegro,
G.; Gómez, M.; Ávila, G. 1992. Importancia relativa de especies cuyo polen es
utilizado por Apis mellifera en el área de la Reserva Nacional de los
Ruiles. VII. Región de Chile. Acta Botánica Malacitana. 17: 174-177.
44. Nuvoloni,
R.; Meucci, V.; Turchi, B.; Sagona, S.; Fratini, F.; Felicioli, A.; Cerri, D.;
Pedonese, F. 2021. Bee-pollen retailed in Tuscany (Italy): Labelling,
palynological, microbiological, and mycotoxicological profile. LWT Food Science
and Technology, 140. DOI: https://doi. org/10.1016/j.lwt.2020.110712
45. O’Neal, R.
J.; Waller, G. D. 1984. On the pollen harvest by the honey bee (Apis
mellifera) near Tucson, Arizona (1976-1981). Desert Plants. 6: 81-109.
46. Pla Dalmau,
J. M. 1961. Polen. Talleres Gráficos D. C. P. Gerona.
47. Puig, Y.;
del Risco, C. A.; Leyva Castillo, V.; Martino, T. K.; Aportela, N.; Hernández,
I.; Oviedo, Y. 2008. Determinación de microorganismos indicadores de la calidad
sanitaria en muestras de polen. Ciencia y Abejas. Año 16(II-63): 2-5.
48.
Rzepecka-Stojko, A.; Stojko, J.; Kurek-Gorecka, A.; Gorecki, M.; Kabala-Dzik,
A.; Kubina, R.; Mozdzierz, A.; Buszman, E. 2015. Polyphenols from bee pollen:
Structure, absorption, metabolism and biological activity. Molecules. 20(12):
21732-21749. DOI: https://doi.org/10.3390/molecules201219800
49. Salamanca
Grosso, G.; Osorio Tangarife, M. P.; Gutiérrez Ortiz, A. M. 2011. Sistema
trazable en el proceso de extracción y beneficio del polen corbicular colectado
por Apis mellifera L. (Hymenoptera: Apidae) en la zona Altoandina de
Boyaca, Colombia. Zootecnia Tropical. 29(1): 127-138.
50. Shephard, G.
S.; Berthiller, F.; Burdaspal, P. A.; Crews, C.; Jonker, M. A.; Krska, R.; Lattanzio,
V. M. T.; MacDonald, S.; Malone, R. J.; Maragos, C.; Sabino, M.; Solfrizzo, M.;
van Egmond, H. P.; Whitaker, T. B. 2013. Developments in mycotoxin analysis: an
update for 2011-2012. World Mycotoxin Journal. 6(1): 3-30.
51. Soares de
Arruda, V. A.; Vieira dos Santos, A.; Figueiredo Sampaio, D.; da Silva Araújo,
E.; de Castro Peixoto, A. L.; Fernandes Estevinho, M. L.; Bicudo de
Almeida-Muradian, L. 2017. Microbiological quality and physicochemical
characterization of Brazilian bee pollen. Journal of Apicultural Research .
56(3): 231-238.
52. Tourn, E.
2013. Recompensas florales de Diplotaxis tenuifolia (L.) DC. Tesis
doctoral. Departamento de Agronomía, Universidad Nacional del Sur, Argentina.
53. Wodehouse,
R. 1935. Pollen grains; their structure, identification and significance in
science and medicine. New York and London: McGraw-Hill Book Company Inc.